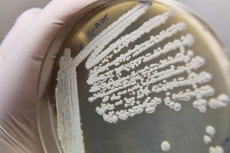

Microbiología
¿Un salto inminente en la investigación microbiológica?
Las bacterias están por todas partes, pero es muy difícil verlas. Los científicos estiman que pueblan el mundo entre 10 y 1.000 millones de especies microbianas diferentes, de las cuales sólo un porcentaje modesto corresponde a especies identificadas. ¿Por qué? Porque la enorme mayoría de microbios no crece en el laboratorio. Esto, a pesar de décadas de los mejores esfuerzos de los científicos por obligar a los organismos microscópicos a entrar en acción.
Ahora, todo apunta a que un nuevo dispositivo permitirá por fin a los microbiólogos aislar y estudiar bacterias de las que hasta ahora muy poco o nada podía averiguarse debido a que solo crecían en el medio natural, mezcladas con otras.
El equipo de Slava Epstein y Ed Goluch, de la Universidad del Nordeste en Boston, Massachusetts, Estados Unidos, ha desarrollado un dispositivo que consta de una cámara interna que contiene una fuente de alimento, y a la que solo se puede entrar a través de un pasillo microscópico por el cual sólo puede pasar una célula bacteriana.
El pasillo es tan pequeño que la primera célula que entra en él se queda atascada, bloqueando la entrada para cualquier otro individuo. La célula atrapada aún es capaz de proliferar, sin embargo, y cuando lo hace llena la cámara interna con una muestra pura de una única especie, la suya.
![[Img #20905]](upload/img/periodico/img_20905.jpg)
El equipo ya ha comprobado la capacidad del dispositivo de separar mezclas de tipos de células. En un experimento, los investigadores separaron dos especies bacterianas diferentes cuyas células tienen tamaños ligeramente distintos, la E. coli y la P. aueruginosa. En un segundo experimento, aislaron una combinación de especies de tamaño similar pero de formas diferentes que habitualmente aparecen juntas en el entorno marino, la Roseobacter sp. y la Pscyhoserpens sp. Por último, utilizaron el dispositivo para separar células de la misma especie que habían sido etiquetadas de forma distinta para brillar ya fuera en rojo o verde. Este experimento valida la hipótesis de que las células que crecen dentro de la cámara con alimento son hijas de la única célula atrapada en la entrada.